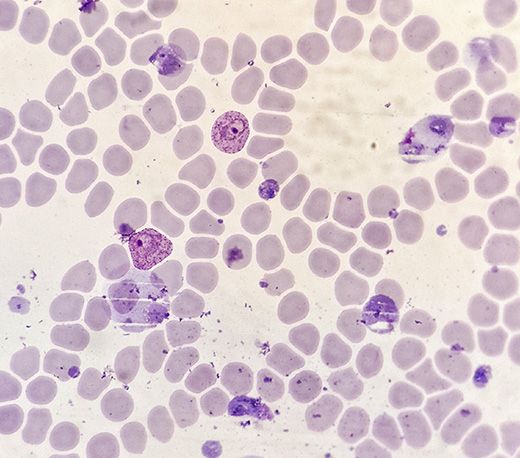
间日疟原虫滋养体,一种疟疾血液寄生虫

Evident定制解决方案团队可以与您共同合作,一起来创建解决方案,从而解决特定的显微镜问题或增强标准显微镜的功能。在此,我们展示了如何通过在偏远地区进行显微镜学培训,在传统功能的基础上更上一层楼。
据估计,全世界有超过2.4亿疟疾病例,导致62.7万人死亡(2020年统计数据)。约有95%的死亡病例出现在非洲。1
为了缓解患者病情,并防止这一蚊媒疾病的传播,疟疾患者应得到尽快治疗。在受疟疾影响严重的地区,建议在24小时内接受治疗。2为了高效且准确地识别引起疟疾的寄生虫,评估样本的实验室人员需要经过充分的培训。此外,如果怀疑是疟疾但评估错误,那么患有其他疾病的病人可能无法得到适当治疗。因此,在对抗疟疾的斗争中,将训练有素的卫生工作者部署在适当的位置尤为重要。
要用显微镜识别疟原虫,首先需由显微镜技术人员对血滴进行染色。常用吉姆萨染色法,可以让疟原虫更加明显。之后,将染色后的血样涂抹在显微镜载玻片上,在显微镜下检查是否存在疟原虫,如图1所示。
图1.间日疟原虫滋养体,一种引起疟疾的寄生虫。
为支持快速评估,配备显微镜的卫生机构尽可能靠近撒哈拉以南非洲地区的高危社区。与设备齐全同样重要的是,当地机构还需要配备经过专业培训的显微镜技术人员来充分利用这些设备。
CX23生物显微镜广泛用于培训和教育领域(图2)。凭借用户友好、轻巧、紧凑和耐用性高的设计特点,CX23显微镜成为偏远地区教育设施的实用之选。而先进的光学技术更使其在成像性能上与众不同。

图2.CX23显微镜非常适合用于培训,并且其人体工学设计能够缓解在实验室长时间观察样本时的不适。
在大多数实验室培训环境中,通常使用由市电供电的集成LED灯对标准CX23型号显微镜上的测试样本进行照明。然而,在一些偏远地区,主电源的可用性和可靠性不尽相同。如果在显微镜培训期间主电源长时间受到干扰,那么显微镜技术人员的资格认证可能会被耽搁较长时间。
欧洲、中东和非洲(EMEA)的Evident销售和定制解决方案团队与非洲的医疗培训机构合作寻求解决方案,以期在长时间停电或没有现成电力供应的地区,也能继续对显微镜技术人员进行培训。
该解决方案如图3所示,是一个便携式USB LED光源,此光源可以轻松连接到CX23显微镜上。提供多种连接选项,使得显微镜技术人员可以根据其选择灵活配置检查。

图3.安装在CX23显微镜上并与太阳能电池板电源连接的USB LED灯的图像。
定制解决方案团队与专业的照明技术供应商合作,确保该光源可以使用普遍使用的USB移动电源运行长达10小时。这样一来,显微镜技术人员可以接受长时间培训。
电池供电的光源具有与内置CX23 LED光源相当的均匀照明和色温,能够保持光学性能,并最终保证诊断的质量。这一点可以从图4的并排对比中看出。

图4.显微镜图像显示了CX23集成LED和定制便携式USB光源在一系列不同放大倍数下的相同图像质量。
在正常条件下运行时,光源的使用寿命可达8年。而且,符合人体工程学的亮度控件使得操作人员能够轻松地优化光线强度。
来自南非Evident分销商Wirsam
Scientific的合作者在测试了该光源之后,是这样评价的:“我们所在的地区,目前正遭遇轮流停电和频繁的计划外停电。我们在CX23显微镜上使用了电池供电LED光源,该光源具有两种配置,既可以连接到显微镜的底座上,也可以插入聚光镜中。我们发现,光强度是足够的。

图5.Wirsam Scientific的配置使用太阳能电池板为USB照明系统供电。
我们已经连续使用该系统超过8小时,其光照强度保持不变。我们甚至将LED光源直接与太阳能电池板一起使用,效果非常好(图5)。生活在一个阳光充足的大陆上,这是一种高效且经济实用的选择。在非洲一些没有电或电力供应不稳定的偏远地区,太阳能电池板可以解决一部分供电难题。”
这种高质量的定制解决方案看似简单,但体现了Evident公司致力于提供生命科学和工业解决方案,帮助世界变得更加安全和健康的承诺。
深入了解我们的定制解决方案团队如何与客户共同创建适合其检验需求的解决方案。
深入了解我们的定制解决方案团队如何与客户共同创建适合其检验需求的解决方案。
仅在部分地区提供该服务。详情请咨询当地销售代表。
1https://www.who.int/teams/global-malaria-programme/reports/world-malaria-report-2021
2https://www.cdc.gov/malaria/malaria_worldwide/reduction/dx_tx.html
Please adjust your selection to be no more than 5 items to compare at once
对不起,此内容在您的国家不适用。
您即将被转换到我们的本地网站。